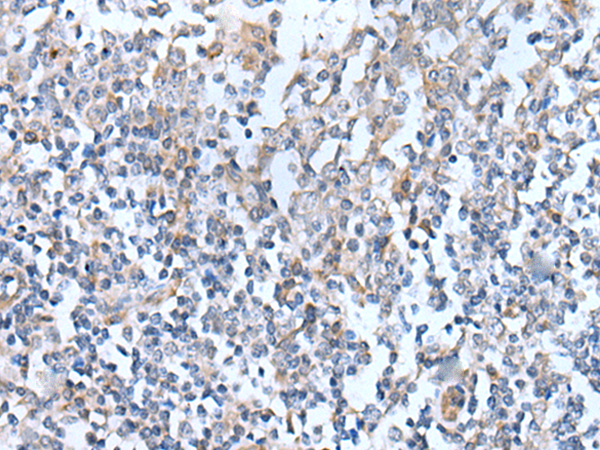
一抗

|
Background: |
Fatty acid-binding proteins, designated FABPs, are a family of homologous cytoplasmic proteins that are expressed in a highly tissue-specific manner and play an integral role in the balance between lipid and carbohydrate metabolism. FABPs mediate fatty acid (FA) and/or hydrophobic ligand uptake, transport and targeting within their respective tissues. The mechanisms underlying these actions can give rise to both passive diffusional uptake and protein-mediated transmembrane transport of FAs. FABP12 (fatty acid-binding protein 12) is a 132 amino acid protein that belongs to the calycin superfamily and fatty-acid binding protein family. Highly expressed in adult retina and testis, FABP12 may function in lipid transport. The gene encoding FABP12 maps to mouse chromosome 3 A1. |
|
Applications: |
ELISA, IHC |
|
Name of antibody: |
FABP12 |
|
Immunogen: |
Synthetic peptide of human FABP12 |
|
Full name: |
fatty acid binding protein 12 |
|
SwissProt: |
A6NFH5 |
|
ELISA Recommended dilution: |
5000-10000 |
|
IHC positive control: |
Human colorectal cancer and human tonsil |
|
IHC Recommend dilution: |
25-100 |


 購物車
購物車 幫助
幫助
 021-54845833/15800441009
021-54845833/15800441009